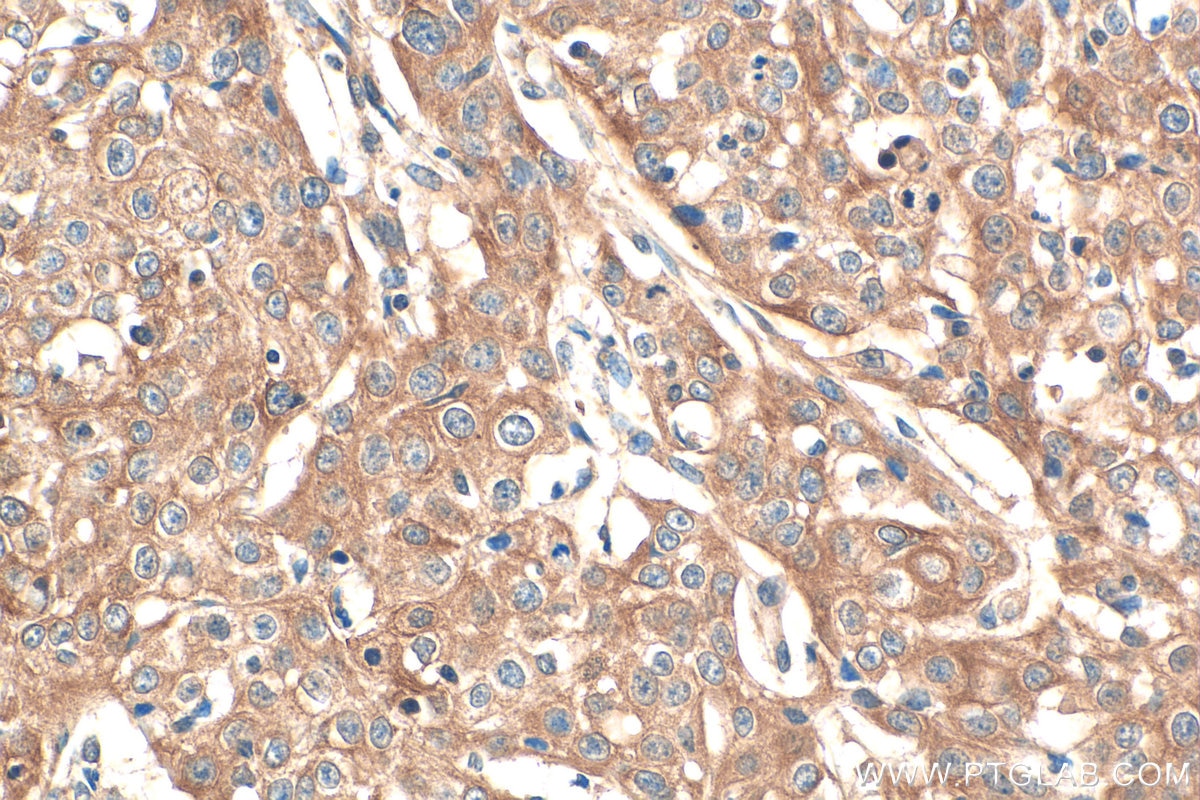
IHC staining of human cervical cancer using 13797-1-AP Immunohistochemistry (IHC) staining of human cervical cancer tissue using Pentraxin 3 Polyclonal antibody (13797-1-AP)
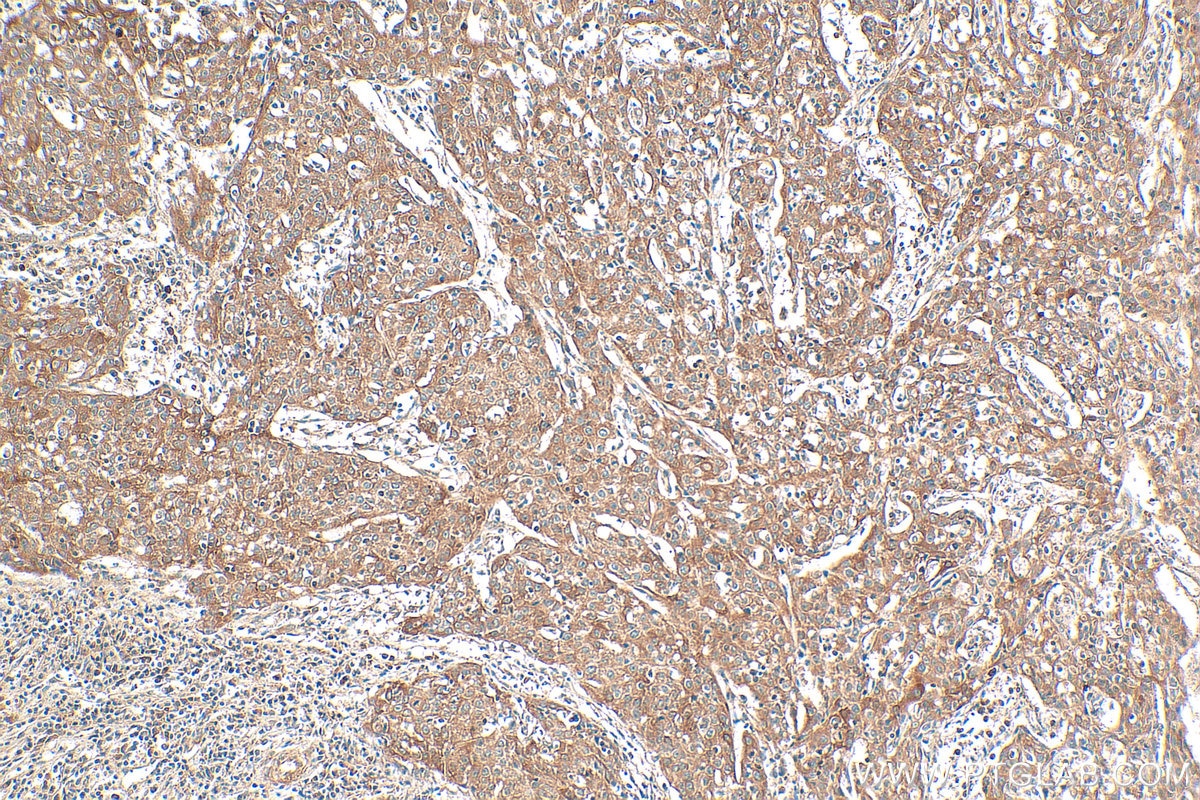
IHC staining of human cervical cancer using 13797-1-AP Immunohistochemistry (IHC) staining of human cervical cancer tissue using Pentraxin 3 Polyclonal antibody (13797-1-AP)

Tested Applications
| Positive WB detected in | HUVEC cells, HeLa cells, HepG2 cells |
| Positive IHC detected in | human cervical cancer tissue Note: suggested antigen retrieval with TE buffer pH 9.0; (*) Alternatively, antigen retrieval may be performed with citrate buffer pH 6.0 |
| Positive IF-P detected in | human placenta tissue |
| Positive IF/ICC detected in | HepG2 cells |
Recommended dilution
| Application | Dilution |
|---|---|
| Western Blot (WB) | WB : 1:500-1:2000 |
| Immunohistochemistry (IHC) | IHC : 1:50-1:500 |
| Immunofluorescence (IF)-P | IF-P : 1:200-1:800 |
| Immunofluorescence (IF)/ICC | IF/ICC : 1:200-1:800 |
| It is recommended that this reagent should be titrated in each testing system to obtain optimal results. | |
| Sample-dependent, Check data in validation data gallery. | |
Published Applications
| KD/KO | See 8 publications below |
| WB | See 34 publications below |
| IHC | See 16 publications below |
| IF | See 15 publications below |
Product Information
13797-1-AP targets Pentraxin 3 in WB, IHC, IF/ICC, IF-P, ELISA applications and shows reactivity with human, mouse samples.
| Tested Reactivity | human, mouse |
| Cited Reactivity | human, mouse, rat, bovine |
| Host / Isotype | Rabbit / IgG |
| Class | Polyclonal |
| Type | Antibody |
| Immunogen |
CatNo: Ag4624 Product name: Recombinant human PTX3 protein Source: e coli.-derived, PGEX-4T Tag: GST Domain: 22-381 aa of BC039733 Sequence: DYDLMYVNLDNEIDNGLHPTEDPTPCDCGQEHSEWDKLFIMLENSQMRERMLLQATDDVLRGELQRLREELGRLAESLARPCAPGAPAEARLTSALDELLQATRDAGRRLARMEGAEAQRPEEAGRALAAVLEELRQTRADLHAVQGWAARSWLPAGCETAILFPMRSKKIFGSVHPVRPMRLESFSACIWVKATDVLNKTILFSYGTKRNPYEIQLYLSYQSIVFVVGGEENKLVAEAMVSLGRWTHLCGTWNSEEGLTSLWVNGELAATTVEMATGHIVPEGGILQIGQEKNGCCVGGGFDETLAFSGRLTGFNIWDSVLSNEEIRETGGAESCHIRGNIVGWGVTEIQPHGGAQYVS Predict reactive species |
| Full Name | pentraxin-related gene, rapidly induced by IL-1 beta |
| Calculated Molecular Weight | 381 aa, 42 kDa |
| Observed Molecular Weight | 40-45 kDa |
| GenBank Accession Number | BC039733 |
| Gene Symbol | Pentraxin 3/PTX3 |
| Gene ID (NCBI) | 5806 |
| RRID | AB_2165302 |
| Conjugate | Unconjugated |
| Form | Liquid |
| Purification Method | Antigen affinity purification |
| UNIPROT ID | P26022 |
| Storage Buffer | PBS with 0.02% sodium azide and 50% glycerol, pH 7.3. |
| Storage Conditions | Store at -20°C. Stable for one year after shipment. Aliquoting is unnecessary for -20oC storage. 20ul sizes contain 0.1% BSA. |
Background Information
Pentraxin 3 (PTX3), also known as TNF-inducible gene 14 protein (TSG-14), is a member of the pentraxin superfamily which consists of evolutionarily conserved proteins characterized by a structural motif99, the pentraxin domain (PMID: 15771574). Pentraxin 3 can be produced by a variety of cell types including endothelial cells, smooth muscle cells, adipocytes, fibroblasts, mononuclear phagocytes, and dendritic cells, and its expression is induced by primary inflammatory signals, such as IL-1, TNF, and microbial moieties (PMID: 15771574). Pentraxin 3 is an acute-phase glycoprotein that plays a role in regulating innate resistance to pathogens, inflammation, tissue remodeling and repair, female fertility, and cancer (PMID: 29412047). Pentraxin 3 is a biomarker for cardiovascular disease (PMID: 22347626). Increased plasma Pentraxin 3 levels have been found in patients with cardiovascular disorders (PMID: 22347626; 31057548). In WB, there're two major bands, an upper signal at 80-86 kDa and a lower signal at 42 kDa, representing Pentraxin 3 dimers and monomers, respectively (PMID: 18223257).
Protocols
| Product Specific Protocols | |
|---|---|
| IF protocol for Pentraxin 3 antibody 13797-1-AP | Download protocol |
| IHC protocol for Pentraxin 3 antibody 13797-1-AP | Download protocol |
| WB protocol for Pentraxin 3 antibody 13797-1-AP | Download protocol |
| Standard Protocols | |
|---|---|
| Click here to view our Standard Protocols |
Publications
| Species | Application | Title |
|---|---|---|
J Clin Invest Chromosomal 3q amplicon encodes essential regulators of secretory vesicles that drive secretory addiction in cancer | ||
Neuron Spatiotemporal transcriptomic maps of mouse intracerebral hemorrhage at single-cell resolution | ||
Nat Commun SH3RF3 promotes breast cancer stem-like properties via JNK activation and PTX3 upregulation. | ||
Front Cell Dev Biol Pentraxin 3 Promotes Glioblastoma Progression by Negative Regulating Cells Autophagy. | ||
Ecotoxicol Environ Saf PTX3 alleviates hard metal-induced acute lung injury through potentiating efferocytosis. |
Reviews
The reviews below have been submitted by verified Proteintech customers who received an incentive for providing their feedback.
FH Karla (Verified Customer) (02-18-2026) | Yes, antibody worked ok in endothelial cells at this dilution. Probably will use more dilute next time.
|